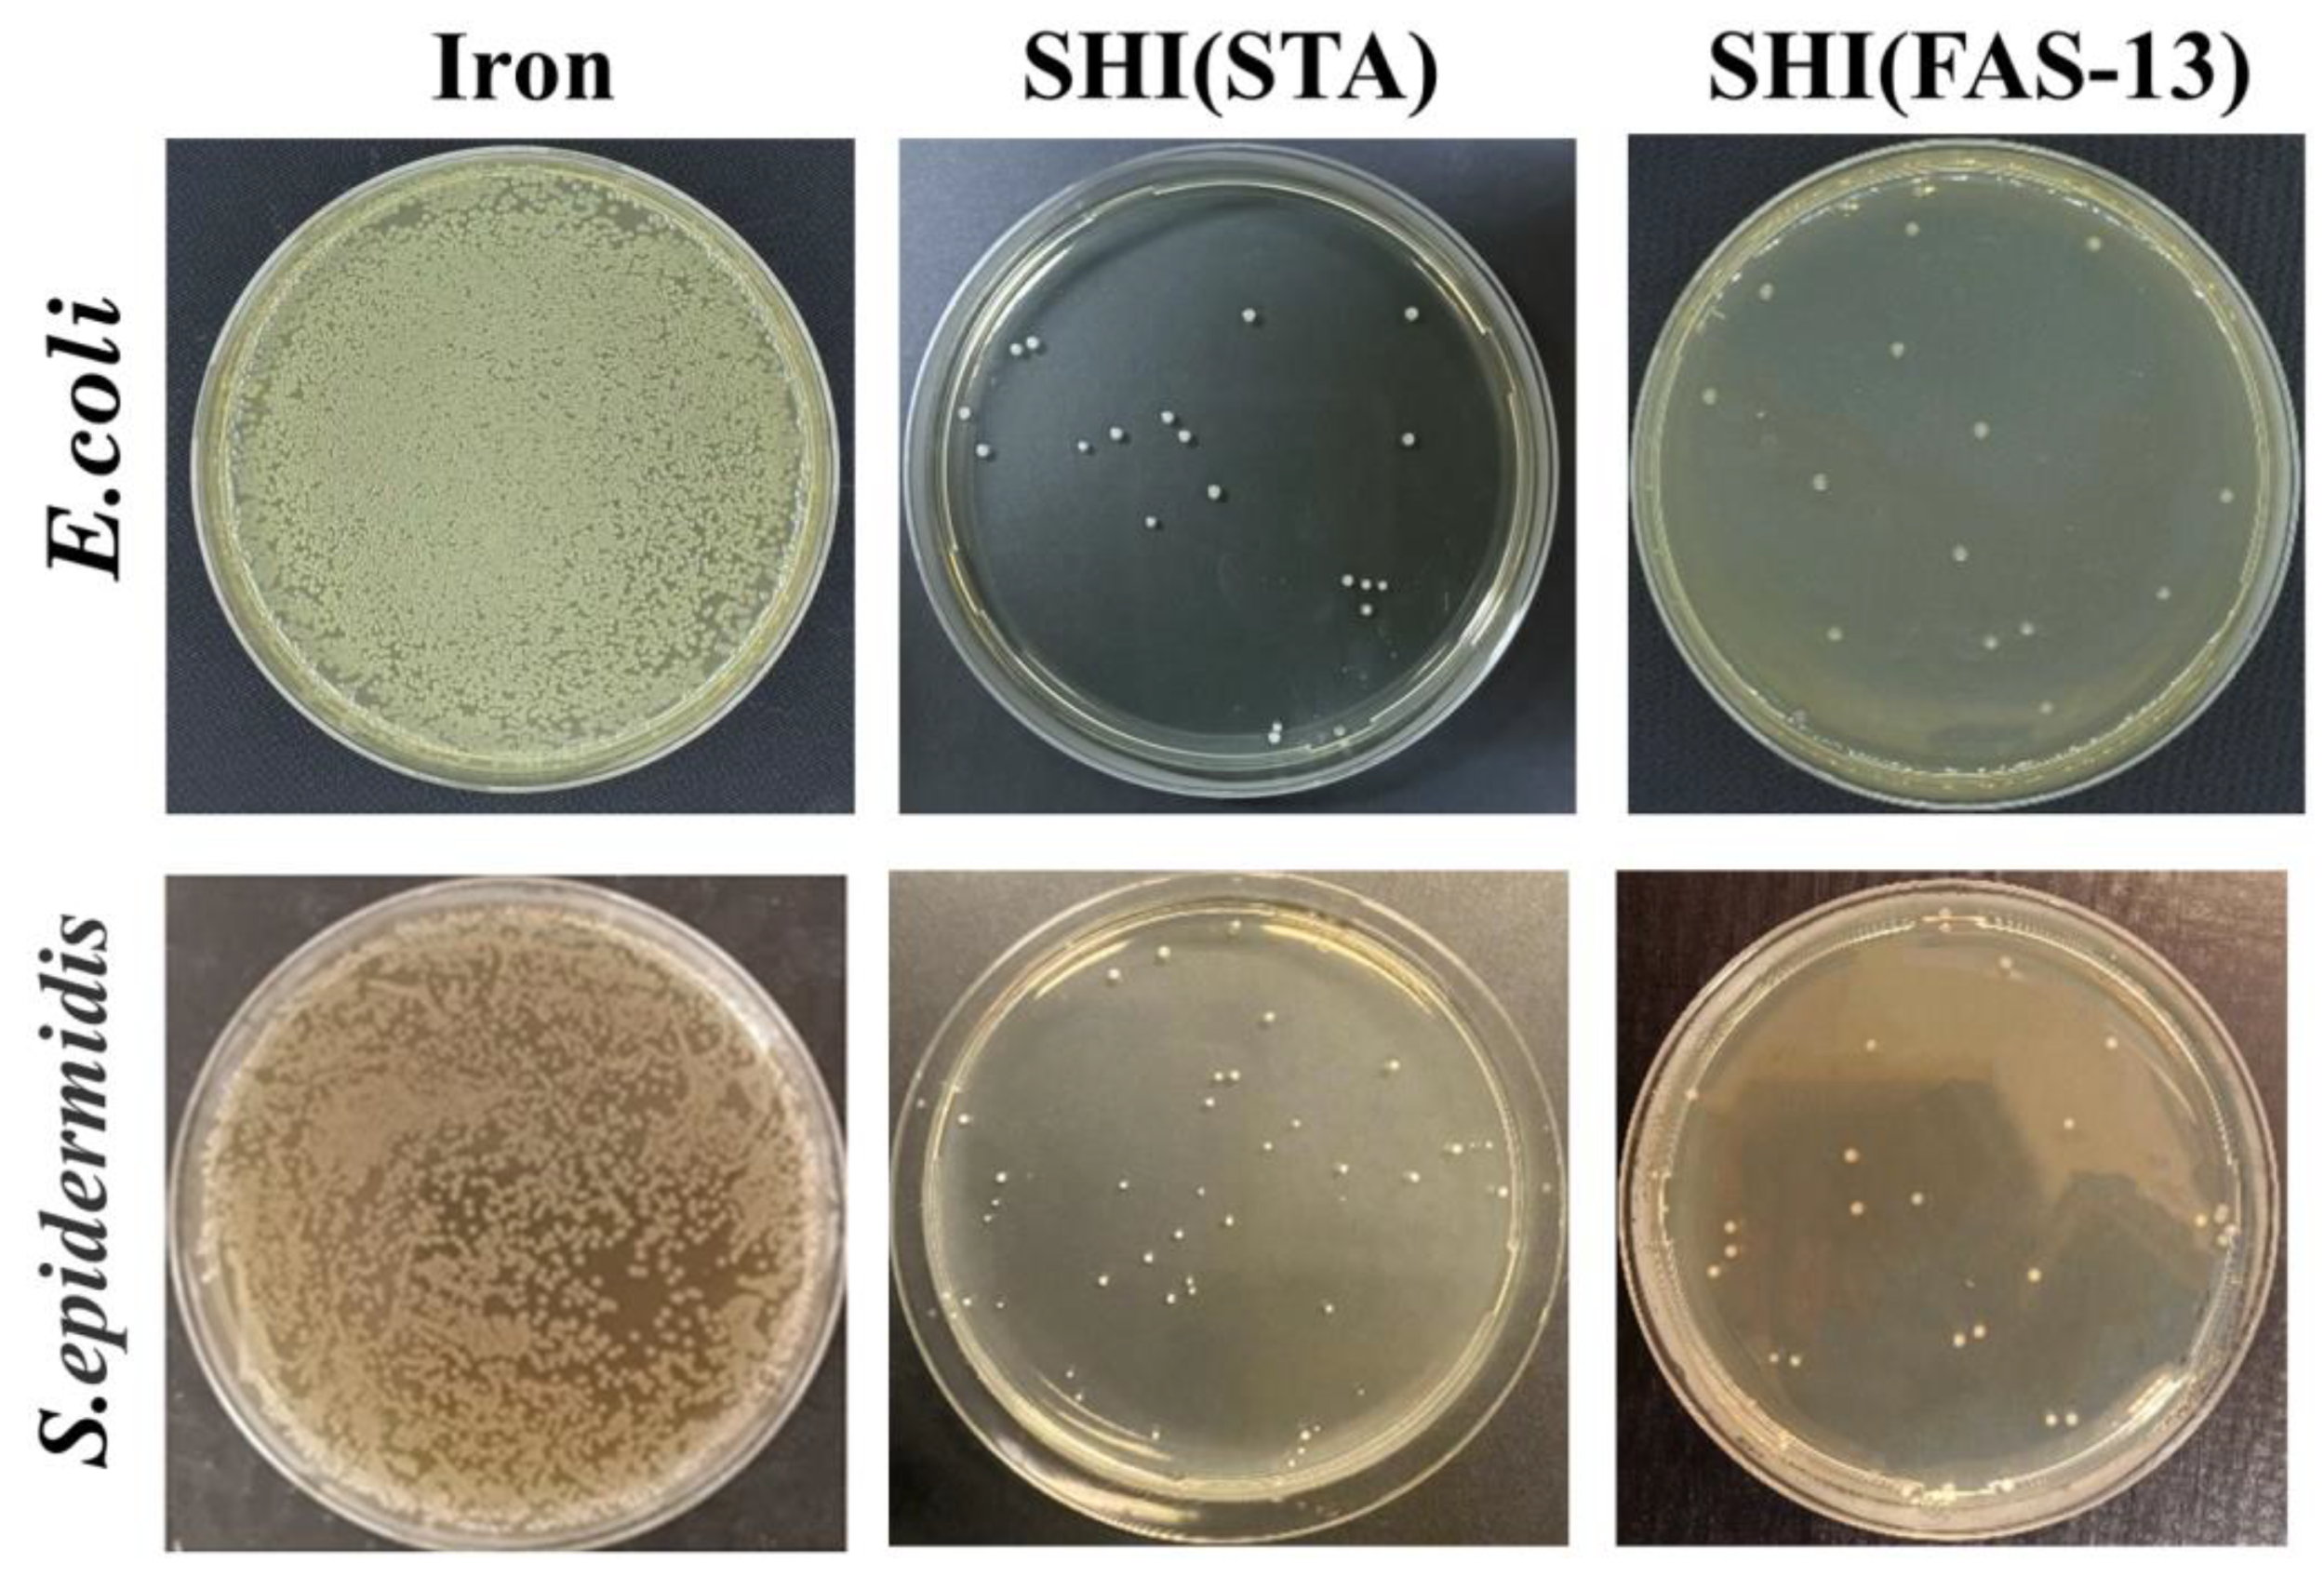
Materials 15 08634 g008 Materials 15 08634 g008

Construction of Superhydrophobic Coating on Iron Surface with Enhanced Anti-Corrosion, Anti-Adhesive and Anti-Bacterial Properties
Abstract
1. Introduction
2. Materials and Methods
2.1. Materials and Characterization
2.2. Preparation of Superhydrophobic Coating on Iron Surface
2.3. Anti-Condensation Performance
2.4. Anti-Platelet Adhesion Test
2.5. Electrochemical Corrosion Test
2.6. Anti-Bacterial Test
3. Results and Discussion
3.1. Surface Morphology, Composition and Wetting Properties
3.2. Anti-Condensation Performance
3.3. Self-Cleaning Performance and Anti-Platelet Adhesion Properties
3.4. Electrochemical Corrosion Test
3.5. Anti-Bacterial Properties
4. Conclusions
Author Contributions
Funding
Institutional Review Board Statement
Informed Consent Statement
Data Availability Statement
Conflicts of Interest
References
- Hatte, S.; Pitchumani, R. Analysis of convection heat transfer on multiscale rough superhydrophobic and liquid infused surfaces. Chem. Eng. J. 2021, 424, 130256. [Google Scholar] [CrossRef]
- Ali, N.; Bilal, M.; Khan, A.; Ali, F.; Ibrahim, M.N.M.; Gao, X.; Zhang, S.; Hong, K.; Iqbal, H.M.N. Engineered hybrid materials with smart surfaces for effective mitigation of petroleum-originated pollutants. Engineering 2021, 7, 1492–1503. [Google Scholar] [CrossRef]
- Ju, G.; Zhou, L.; Jiao, C.; Shen, J.; Luan, Y.; Zhao, X. One-step fabrication of a functionally integrated device based on polydimethylsiloxane-coated SiO2 NPs for efficient and continuous oil absorption. Materials 2021, 14, 5998. [Google Scholar] [CrossRef] [PubMed]
- Zhang, R.; Zhou, Z.; Ge, W.; Lu, Y.; Liu, T.; Yang, W.; Dai, J. Robust, fluorine-free and superhydrophobic composite melamine sponge modified with dual silanized SiO2 microspheres for oil–water separation. Chin. J. Chem. Eng. 2021, 33, 50–60. [Google Scholar] [CrossRef]
- Fu, H.; Liu, S.; Yi, L.; Jiang, H.; Li, C.; Chen, Y. A durable and self-cleaning superhydrophobic surface prepared by precipitating flower-like crystals on a glass-ceramic surface. Materials 2020, 13, 1642. [Google Scholar] [CrossRef]
- Niu, W.; Chen, G.Y.; Xu, H.; Liu, X.; Sun, J. Highly transparent and self-healable solar thermal anti-/deicing surfaces: When ultrathin MXene multilayers marry a solid slippery self-cleaning coating. Adv. Mater. 2022, 34, 2108232. [Google Scholar] [CrossRef]
- Wang, D.; Zhu, L.; Chen, J.-F.; Dai, L. Liquid marbles based on magnetic upconversion nanoparticles as magnetically and optically responsive miniature reactors for photocatalysis and photodynamic therapy. Angew. Chem. Int. Ed. 2016, 55, 10795–10799. [Google Scholar] [CrossRef] [PubMed]
- Wang, D.; Liu, J.; Chen, J.-F.; Dai, L. Surface functionalization of carbon dots with polyhedral oligomeric silsesquioxane (POSS) for multifunctional applications. Adv. Mater. Interfaces 2016, 3, 1500439. [Google Scholar] [CrossRef]
- Zhao, Z.; Yao, X.; Zhao, W.; Shi, B.; Sridhar, S.; Pu, Y.; Pramana, S.; Wang, D.; Wang, S. Highly transparent liquid marble in liquid (HT-LMIL) as 3D miniaturized reactor for real-time bio-/chemical assays. Chem. Eng. J. 2022, 443, 136417. [Google Scholar] [CrossRef]
- Yang, F.; Zhou, W.; Li, F.; Yuan, L.; Diao, Y.; Liu, Y.; Pu, Y.; Zhang, Y.; Zhao, Y.; Jiang, O.; et al. Sprayable coating based on fluorinated silica nanocomposites with superhydrophobic and antibacterial properties for advanced concrete. Prog. Nat. Sci.-Mater. 2022, 32, 472–481. [Google Scholar] [CrossRef]
- Mohamed, A.M.A.; Hasan, H.; Seleman, M.M.E.-S.; Ahmed, E.; Saleh, S.M.; EI-Maghraby, E.M. Performance of sprayed PVDF-Al2O3 composite coating for industrial and civil applications. Materials 2021, 14, 6358. [Google Scholar] [CrossRef] [PubMed]
- Quaranta, E.; Davies, P. Emerging and innovative materials for hydropower engineering applications: Turbines, bearings, sealing, dams and waterways, and ocean power. Engineering 2022, 8, 148–158. [Google Scholar] [CrossRef]
- Saji, V.S. Superhydrophobic surfaces and coatings by electrochemical anodic oxidation and plasma electrolytic oxidation. Adv. Colloid. Interface Sci. 2020, 283, 102245. [Google Scholar]
- Jeevahan, J.; Chandrasekaran, M.; Britto Joseph, G.; Durairaj, R.B.; Mageshawaran, G. Superhydrophobic surfaces: A review on fundamentals, applications, and challenges. J. Coat. Technol. Res. 2018, 15, 231–250. [Google Scholar] [CrossRef]
- Pearce, H.A.; Mikos, A.G. Machine learning and medical devices: The next step for tissue engineering. Engineering 2021, 7, 1704–1706. [Google Scholar] [CrossRef]
- Palmer, C. Shrinking medical devices get smarter too. Engineering 2021, 7, 8–10. [Google Scholar] [CrossRef]
- Fuchs-Godec, R. Flower-like superhydrophobic surfaces fabricated on stainless steel as a barrier against corrosion in simulated acid rain. Materials 2022, 15, 7104. [Google Scholar] [CrossRef] [PubMed]
- Chouirfa, H.; Bouloussa, H.; Migonney, V.; Falentin-Daudre, C. Review of titanium surface modification techniques and coatings for antibacterial applications. Acta Biomater. 2019, 83, 37–54. [Google Scholar]
- Wei, T.; Yu, Q.; Chen, H. Responsive and synergistic antibacterial coatings: Fighting against bacteria in a smart and effective way. Adv. Healthc. Mater. 2019, 8, e1801381. [Google Scholar] [CrossRef]
- Avcu, E.; Baştan, F.E.; Abdullah, H.Z.; Rehman, M.A.U.; Avcu, Y.Y.; Boccaccini, A.R. Electrophoretic deposition of chitosan-based composite coatings for biomedicalapplications: A review. Prog. Mater. Sci. 2019, 103, 69–108. [Google Scholar] [CrossRef]
- Pu, Y.; Lin, L.; Liu, J.; Wang, J.-X.; Wang, D. High-gravity-assisted green synthesis of rare-earth doped calcium molybdate colloidal nanophosphors. Chin. J. Chem. Eng. 2020, 28, 1744–1751. [Google Scholar] [CrossRef]
- Wang, Z.; Zhao, Z.; Baucom, J.; Wang, D.; Dai, L.; Chen, J.-F. Nitrogen-doped graphene foam as a metal-free catalyst for reduction reactions under a high gravity field. Engineering 2020, 6, 680–687. [Google Scholar] [CrossRef]
- Zhang, W.; Wang, D.; Wang, J.-X.; Pu, Y.; Chen, J.-F. High-gravity-assisted emulsification for continuous preparation of waterborne polyurethane nanodispersion with high solids content. Front. Chem. Sci. Eng. 2020, 14, 1087–1099. [Google Scholar] [CrossRef]
- He, X.; Tang, R.; Yang, F.; Kadhihm, M.S.; Wang, J.-X.; Pu, Y.; Wang, D. Zirconia quantum dots for a nonvolatile resistive random access memory device. Front. Inform. Technol. Electron. Eng. 2019, 20, 1698–1705. [Google Scholar] [CrossRef]
- Chen, T.; Yan, W.; Hongtao, L.; Zhu, W.; Guo, K.; Li, J. Facile preparation of superamphiphobic phosphate–Cu coating on iron substrate with mechanical stability, anti-frosting properties, and corrosion resistance. J. Mater. Sci. 2017, 52, 4675–4688. [Google Scholar] [CrossRef]
- de Bouwa, M.; Woutersa, I.; Vereeckenb, J.; Lauriksa, L. Iron and steel varieties in building industry between 1860 and 1914—A complex and confusing situation resolved. Constr. Build. Mater. 2009, 23, 2775–2787. [Google Scholar] [CrossRef]
- Nasution, A.K.; Murni, N.S.; Sing, N.B.; Idris, M.H.; Hermawan, H. Partially degradable friction-welded pure iron–stainless steel 316L bone pin. J. Biomed. Mater. Res. 2014, 103, 31–38. [Google Scholar] [CrossRef] [PubMed]
- Dwivedi, S.; Dixit, A.R.; Das, A.K. Wetting behavior of selective laser melted (SLM) bio-medical grade stainless steel 316L. Mater. Today Proc. 2022, 56, 46–50. [Google Scholar] [CrossRef]
- Hu, J.; He, S.; Wang, Z.; Zhu, J.; Wei, L.; Chen, Z. Stearic acid-coated superhydrophobic Fe2O3/Fe3O4 composite film on N80 steel for corrosion protection. Surf. Coat. Tech. 2019, 359, 47–54. [Google Scholar] [CrossRef]
- Tao, C.; Liu, H.; Su, S.; Xie, J.; Ma, Y. Preparation of superhydrophobic magnetic stearic acid polyurethane sponge for oil–water separation. J. Mater. Res. 2020, 35, 2925–2935. [Google Scholar]
- Song, J.; Wang, D.; Hu, L.; Huang, X.; Chen, Y. Superhydrophobic surface fabricated by nanosecond laser and perhydropolysilazane. Appl. Sur. Sci. 2018, 455, 771–779. [Google Scholar] [CrossRef]
- Zhao, Z.; Wang, Z.; Wang, D.; Wang, J.-X.; Foster, N.R.; Pu, Y.; Chen, J.-F. Preparation of 3D graphene/iron oxides aerogels based on high-gravity intensified reactive precipitation and their applications for photo-Fenton reaction. Chem. Eng. Process. 2018, 129, 77–83. [Google Scholar] [CrossRef]
- Wang, W.; Wang, S.; Yao, D.; Wang, X.; Yu, X.; Zhang, Y. Fabrication of all-dimensional superhydrophobic mortar with enhanced waterproof ability and freeze-thaw resistance. Constr. Build. Mater. 2020, 238, 117626. [Google Scholar] [CrossRef]
- Wang, H.; Chen, E.; Jia, X.; Liang, L.; Wang, Q. Superhydrophobic coatings fabricated with polytetrafluoroethylene and SiO2 nanoparticles by spraying process on carbon steel surfaces. Appl. Surf. Sci. 2015, 349, 724–732. [Google Scholar] [CrossRef]
- Wang, F.; Zhang, F.; Zheng, L.; Zhang, H. Structure and corrosion properties of Cr coating deposited on aerospace bearing steel. Appl. Surf. Sci. 2017, 423, 695–703. [Google Scholar] [CrossRef]

| Sample | Ecorr (VSCE) | Icorr (μA·cm−2) | (%) |
|---|---|---|---|
| Iron | −0.50 | 0.54 | — |
| Structured iron | −0.55 | 1.44 | −166.67 |
| SHI (STA) | −0.27 | 0.12 | 77.78 |
| SHI (FAS-13) | −0.23 | 0.083 | 84.63 |
| Sample | Rs (Ω·cm2) | Cf (μF·cm−2) | Rf (Ω·cm2) | Cdl (μF·cm−2) | Rct (Ω·cm2) |
|---|---|---|---|---|---|
| Iron | 14.68 | — | — | 180.3 | 250.4 |
| Structured iron | 14.70 | 33.45 | 71.94 | 92.12 | 453.5 |
| SHI (STA) | 17.94 | 2.94 × 10−4 | 231.3 | 591.4 | 7231 |
| SHI (FAS-13) | 17.60 | 3.07 × 10−4 | 246.8 | 805.3 | 9766 |
Publisher’s Note: MDPI stays neutral with regard to jurisdictional claims in published maps and institutional affiliations. |
© 2022 by the authors. Licensee MDPI, Basel, Switzerland. This article is an open access article distributed under the terms and conditions of the Creative Commons Attribution (CC BY) license (https://creativecommons.org/licenses/by/4.0/).
Share and Cite
Zhou, W.; Yang, F.; Yuan, L.; Diao, Y.; Jiang, O.; Pu, Y.; Zhang, Y.; Zhao, Y.; Wang, D. Construction of Superhydrophobic Coating on Iron Surface with Enhanced Anti-Corrosion, Anti-Adhesive and Anti-Bacterial Properties. Materials 2022, 15, 8634. https://doi.org/10.3390/ma15238634
Zhou W, Yang F, Yuan L, Diao Y, Jiang O, Pu Y, Zhang Y, Zhao Y, Wang D. Construction of Superhydrophobic Coating on Iron Surface with Enhanced Anti-Corrosion, Anti-Adhesive and Anti-Bacterial Properties. Materials. 2022; 15(23):8634. https://doi.org/10.3390/ma15238634
Chicago/Turabian StyleZhou, Wuyifan, Feng Yang, Ling Yuan, Yangmin Diao, Ou Jiang, Yuan Pu, Yong Zhang, Yong Zhao, and Dan Wang. 2022. "Construction of Superhydrophobic Coating on Iron Surface with Enhanced Anti-Corrosion, Anti-Adhesive and Anti-Bacterial Properties" Materials 15, no. 23: 8634. https://doi.org/10.3390/ma15238634
APA StyleZhou, W., Yang, F., Yuan, L., Diao, Y., Jiang, O., Pu, Y., Zhang, Y., Zhao, Y., & Wang, D. (2022). Construction of Superhydrophobic Coating on Iron Surface with Enhanced Anti-Corrosion, Anti-Adhesive and Anti-Bacterial Properties. Materials, 15(23), 8634. https://doi.org/10.3390/ma15238634

